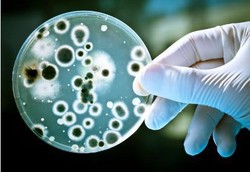
Tiap Masuk Ruangan, 1 Manusia Sumbang 37 Juta Bakteri

detikInet
Telkomsel: Kami Difitnah LSM KTI
Aksi Ketua LSM Konsumen Telekomunikasi Indonesia (KTI) Denny AK dianggap sudah keterlaluan oleh Telkomsel. Bahkan sudah dianggap dalam kadar fitnah. Tak pelak, Telkomsel pun melapor ke Polda Metro Jaya.
Selasa, 01 Mei 2012 13:41 WIB